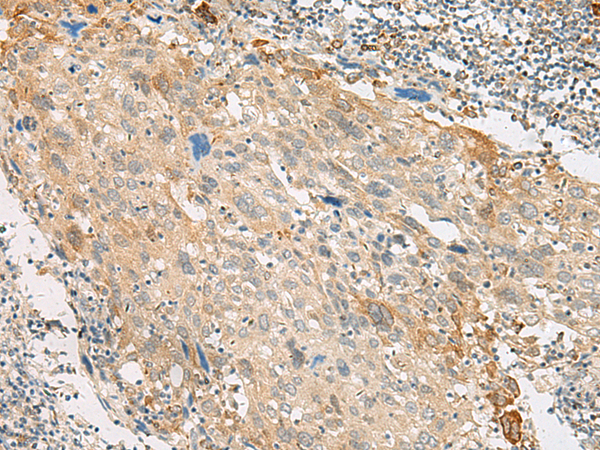

Background:
The protein encoded by this gene is similar to the galanin receptor subfamily of G protein-coupled receptors. The encoded protein is found predominantly in the central nervous system.
Applications:
ELISA, IHC
Name of antibody:
GPR151
Immunogen:
Synthetic peptide of human GPR151
Full name:
G protein-coupled receptor 151
Synonyms:
GPCR; PGR7; GALR4; GALRL; GPCR-2037
SwissProt:
Q8TDV0
ELISA Recommended dilution:
5000-10000
IHC positive control:
Human cervical cancer and Human colorectal cancer
IHC Recommend dilution:
40-200

購(gòu)物車
幫助
021-54845833/15800441009
